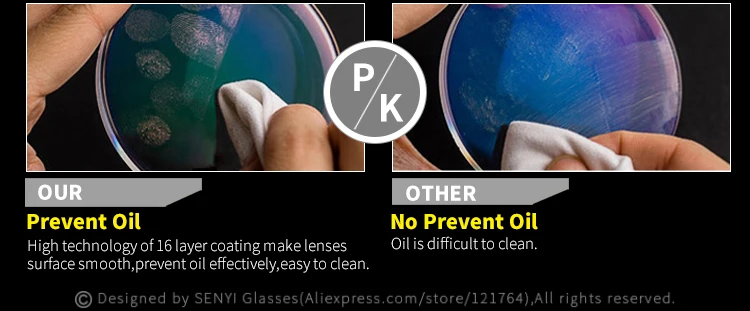

Большой Размеры оправа для очков, Для женщин синий светильник с диоптриями прогрессивные солнцезащитные очки "кошачий глаз", очки в стиле авиатор с прозрачными компьютер близорукость Lentes Opticos 851
5 814,39₽
В наличии!
SENYI GLASSES store - Надежность 97%
Более 2450 подписчиков, дата открытия магазина 28.03.2013
- Положительные оценки: 98% (339)
- Соответствие описанию: 96%
- Отвечает на сообщения: 98%
- Скорость отправки: 96%
Последнее обновление: 01.04.2022
Последнее обновление: 24.03.2022
Женские очки без оправы, без оправы, с декоративным узором в виде б...
3 087,88₽
Последнее обновление: 14.04.2022
Высококачественные очки для чтения, женские компьютерные очки без о...
2 676,24₽
Последнее обновление: 05.06.2022
Очки для чтения мужские титановые, без оправы, светильник оправы
4 672,18₽
Последнее обновление: 18.03.2022
Bluelight Фильтр блокировки Оправы для близорукости, Для женщин очк...
3 639,79₽
Последнее обновление: 31.03.2022
Роскошные качественные титановые очки, Женская оправа без оправы + ...
4 065,15₽ -45%
Последнее обновление: 07.10.2024
Последнее обновление: 11.03.2022
Синий светильник Блокировка близорукость Для женщин очки с диоптрия...
2 812,26₽ -45%
Последнее обновление: 26.09.2024
Очки мужские без оправы для близорукости, оптические аксессуары для...
5 197,23₽
Последнее обновление: 27.03.2022
Антибликовыми свойствами светильник Титан близорукость очки женщин ...
5 392,57₽ -45%
Последнее обновление: 17.03.2022
Фотохромные очки с диоптриями астигматизма, титановый рецепт
4 500,84₽ -49%
Последнее обновление: 11.10.2024
Большие круглые очки без оправы женские очки для близорукости алмаз...
4 935,66₽
Последнее обновление: 10.10.2024

Вопросы еще не задавались...
-
Frame ColorPink/Purple
-
Frame DesignOversized Rimless Glasses
-
Glasses FunctionMatch Plain Glasses/Myopia Glasses/As Decorative
-
Lens MaterialSuper Hard & Multi-coated Resin Lenses
-
Lense FeaturesAnti-reflective,UVA protection,UVB protection,UV400 protection
-
Lenses Color TintNone
-
Lenses SpecialityHigh Hard,High Tenacity,Impact Resistance,Anti scratched,High Clear
-
Processing FeeFree
-
Style DesignElegant/New fashion/Luxury/Casual/Business
-
Вес логистики0.080
-
Каждая упаковка1
-
Материал линзCR-39
-
Материал оправыСплав
-
Минимальная единица измерения100000015
-
Название брендаDUBERY
-
Номер моделиDG851
-
ПолДля женщин
-
Продано Вsell_by_piece
-
ПроисхождениеКитай
-
Размер логистики - высота (см)5
-
Размер логистики - длина (см)17
-
Размер логистики - ширина (см)7





